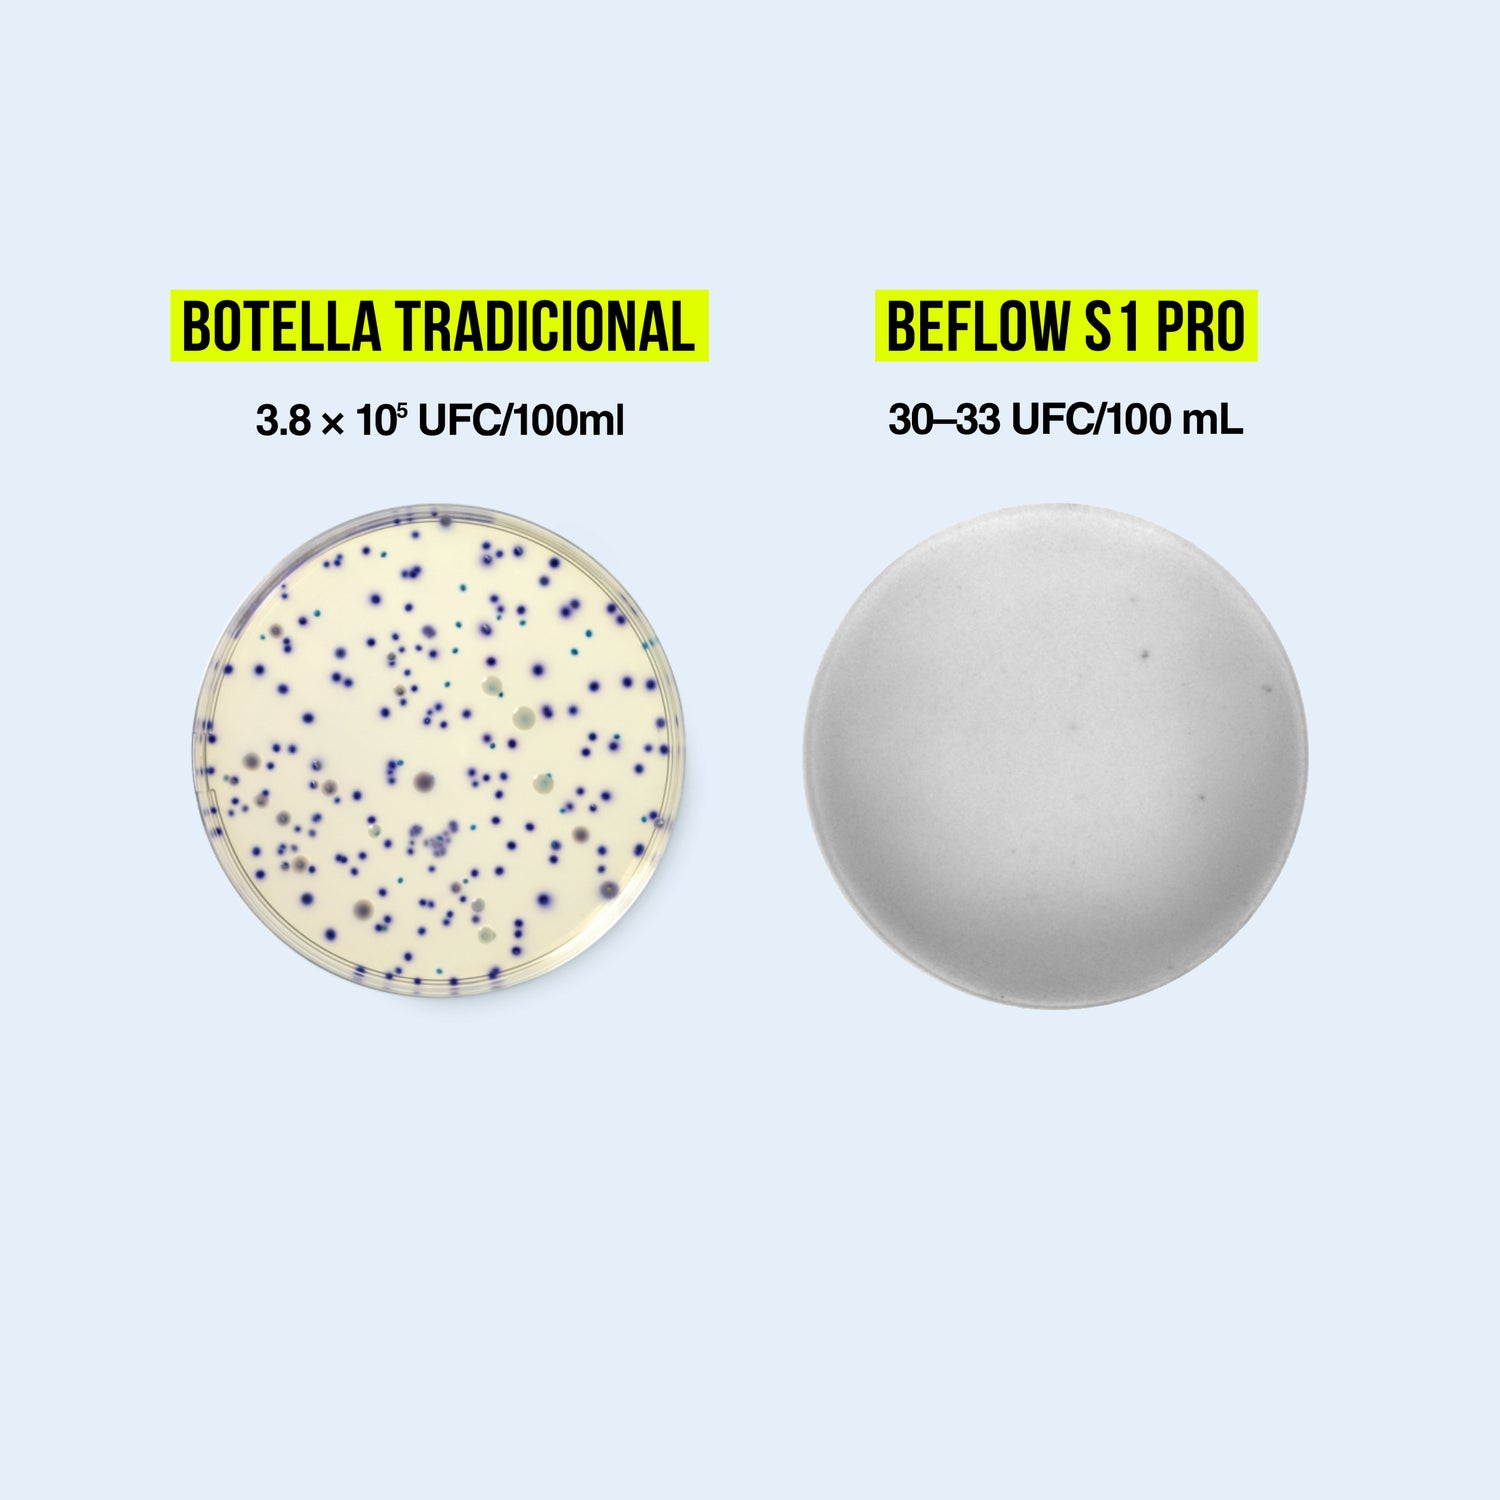

¿QUÉ ES LA ESTERILIZACIÓN UV-C?
La esterilización UV-C es un método de desinfección físico que utiliza luz ultravioleta de onda corta (específicamente en el rango de 200 a 280 nanómetros) para eliminar microorganismos. A diferencia de los métodos químicos, esta tecnología no deja residuos y es altamente eficiente contra virus, bacterias y hongos.